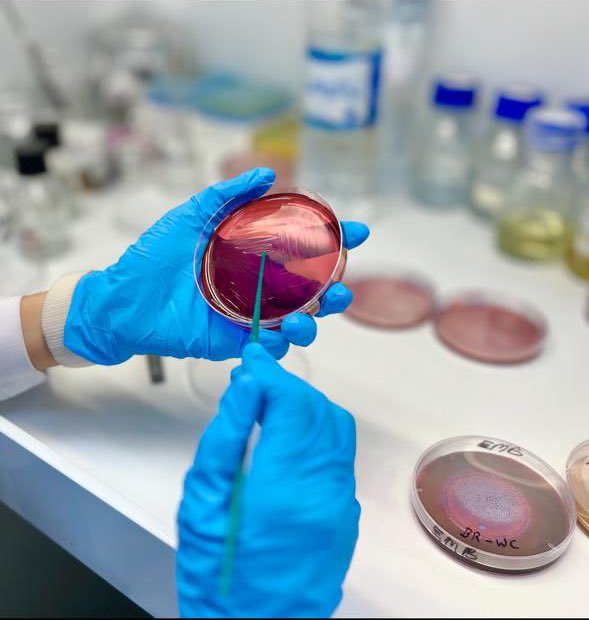
نادي الأحياء | BIOLOGY CLUB (@bioclub_iau) on Twitter photo
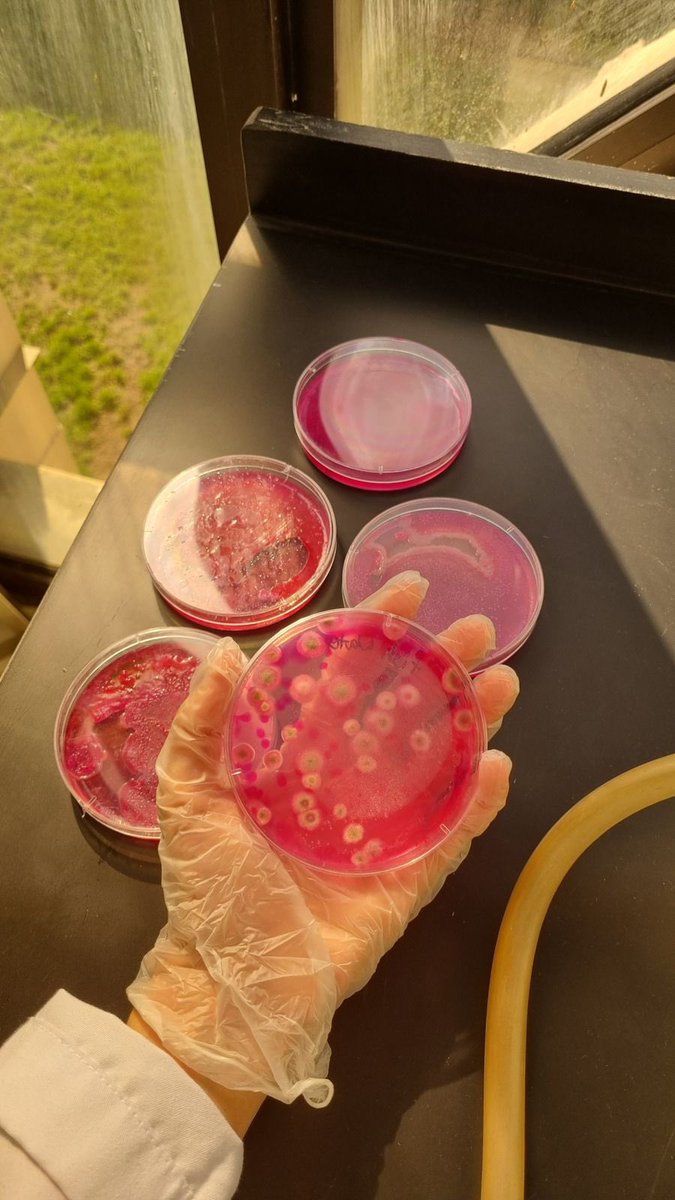
نادي الأحياء | BIOLOGY CLUB (@bioclub_iau) on Twitter photo

Ayesha 🥼
@aishamotiarrhmn
@IAU_cs🔬#Microbiologist 🧫🧬 @KFUPM 🥼🌊 @bioClub_iau 🌱@Nourainclub
اللهم أبي وأمي لايميلان أو يعجزان أو يضيقان أو يحزنان اللهّـم أهلي وعائلتي كـل العمر
ID: 1133876083269484546
29-05-2019 23:21:39
808 Tweet
155 Followers
575 Following